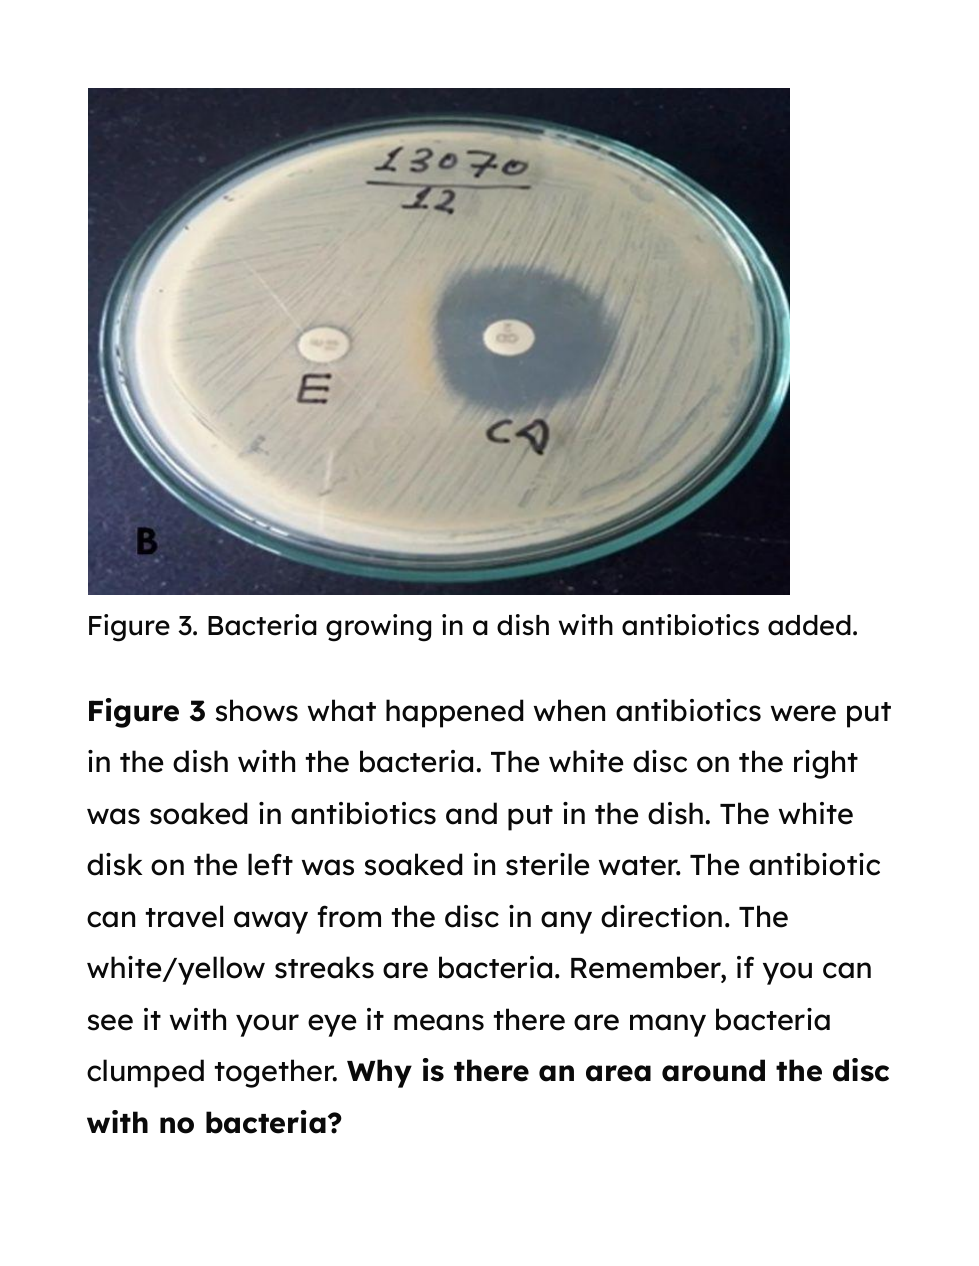

The phenomenon, antibiotic resistance, is the idea that antibiotics that we have used for many years no longer kill the bacteria

Select a claim about bacteria's ability to increase in number, given the images.
Why is there an area around the disc with no bacteria?

How are the bacteria colonies that are now growing near the antibiotic disc different from the bacteria that were killed by the antibiotic?


According to the graphs, what is the relationship between antibiotic use and antibiotic resistance.

Write an explanation using the data evidence to support the claim that antibiotic use causes antibiotic resistance.
You need 2 pieces of evidence from the chart
Scientists developed an antibiotic to fight harmful bacteria that cause infections. After several years of use, the antibiotic became less effective.
Which of the following caused the antibiotic to become less effective?
Which of the following best explains why bacteria are able to adapt to changing environmental conditions?
At Day 3, what do you expect the percent of population non resistant bacteria exposed to antibiotics will be?
At Day 3, what do you expect the percent of population resistant bacteria exposed to antibiotics will be?
At Day 4, what do you expect the percent of population nonresistant bacteria NOT exposed to antibiotics will be?
At Day 4, what do you expect the percent of population resistant bacteria NOT exposed to antibiotics will be?